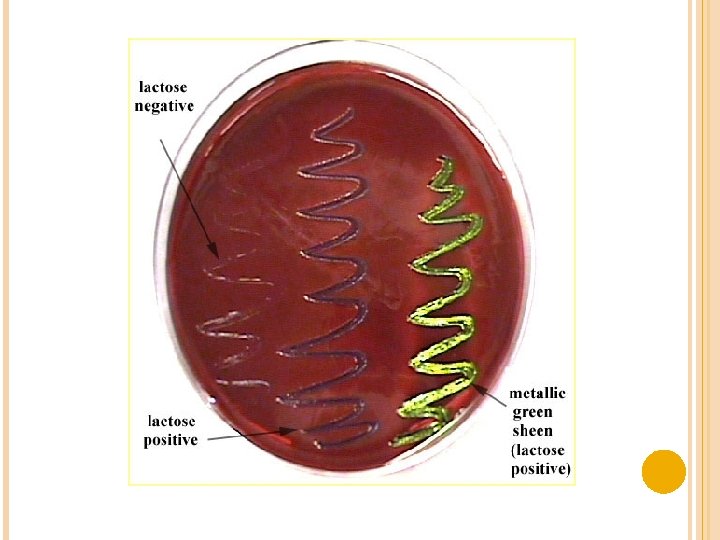

UROCULTIVO EQUIPO 6 4102 C Garca Ruiz Alan





















- Slides: 21

UROCULTIVO

EQUIPO 6 4102 C García Ruiz Alan Jair Hernández Osornio Nancy Hernández Zavala Oscar López Obregón Ana Karina Lucas Pineda Marina Pérez Mendieta Lucia Brenda Romero Galicia Elizabeth

Urocultivo Es el análisis que se le realiza a la orina para detectar con exactitud y precisión cual es el agente microbiano que esta causando una infección en un organismo

La Es orina un liquido biológico considerado estéril debido a su vaciado constante y su p. H ácido que inhibe el desarrollo de algunos microorganismos

INDICACIONES PARA TOMA DE MUESTRA La orina es tomada por el paciente en su domicilio con previo aseo general, haciendo énfasis en los órganos genitales externos. La orina se recolecta en un frasco estéril. No requiere ayuno No beber agua en exceso antes de la recolección de la muestra (al menos 4 horas antes). No estar bajo tratamiento con antibióticos o tener menos de 72 hrs. antes de recolección de muestra. No colocarse medicamentos tópicos (pomada ungüentos o talco), en la región genital, 72 hrs antes de la recolección de muestra. Muestras etiquetadas, nombre y apellido completo, edad, sexo

INDICACIONES DE TOMA DE MUESTRA Paciente pediátrico se recomienda la toma de muestra en el laboratorio, en los niños también se asean los órganos genitales externos y regiones vecinas, se aplica después el dispositivo de Machuca o bolsas de plástico adhesivas. Paciente femenino no estar en menstruación, esta en este periodo deberá esperar días después del termino del periodo para la recolección de la muestra. Paciente con sonda vesical se recomienda que el medico tome la muestra. El urocultivo debe hacerse, dentro de la hora siguiente a la recolección de la orina, o bien si esto no es posible, debe guardarse la orina en el refrigerador a 4°C hasta que pueda cultivarse, sin exceder de algunas horas.

TOMA Una DE MUESTRA vez que se empieza a orinar, se desecha la primera orina que arrastrará los organismos contaminantes. Se interrumpe el paso de la orina para recoger el frasco estéril y recolectar la porción media de la muestra. Y por ultimo se desecha el resto de la orina.


INFECCIÓN DE VÍAS URINARIAS Pielonefritis Vías urinarias altas • Riñones • Uréteres Vías urinarias bajas • Vejiga • Uretra Fiebre Dolor lumbar Disuria (ardor al orinar). Polaquiuria (ir mucho al baño). • Tenesmo (dificultada para orinar). • • Cistitis • Disuria • Dolor

Leucocitos Eritrocitos Células Epiteliales Bacterias

ETIOLOGIA DE LAS INFECCIONES DE VIAS URINARIAS 1. 2. 3. 4. 5. 6. Escherichia Coli (80% al 90% de los casos) Proteus sp. Klebsiella sp. Pseudonoma auruginosa Enterobacter sp. Staphylococcus saprophyticus

ESTIMACIÓN CUANTITATIVA DE LAS COLONIAS La siembra en las placas se realiza por estría cruzada con asas calibradas de 4 mm de diametro y 0. 01 ml de capacidad. Criterio Colonias por ml. Contaminación <10 000 Sospecha de infección 10 000 - 100 000 Infección >100 000 *Hay casos de pielonefritis en los que el número de bacterias es menor de 100 000 en un mililitro de orina. Esos casos se presentan cuando un volumen de orina es muy grande y por lo tanto disminuye la concentración de bacterias en la unidad de volumen.

MÉTODOS Se CUALITATIVOS usan para identificar que microorganismos es el causante de la enfermedad, se usan medios de cultivo tanto enriquecidos como selectivos.

AGAR GELOSA SANGRE Dada la excelente base nutritiva, permite el crecimiento de prácticamente todos los microorganismos que pudieran estar presentes. Si se añade sangre se pueden determinar las distintas formas de hemólisis que pudieran tener lugar.

AGAR GELOSA CHOCOLATE El Agar Gelosa Chocolate es un medio utilizado con varios suplementos para el aislamiento y cultivo de Neisseria gonorrhoeae y otros microorganismos fastidiosos. La hemoglobina al 2% provee la hemina (Factor X) requerida para el crecimiento de Haemophilus y mejorar el desarrollo de Neisseria, así como suplementos (disponibles comercialmente) que proveen glutamina, cocarboxilasa, levadura, glutamina, coenzimas, hemina, vitaminas, aminoácidos, dextrosa y otros factores de crecimiento, todos ellos necesarios para el mejor desarrollo de Haemophilus y Neisseria.

Haemophilus influenzae: Colonias pequeñas, húmedas, perladas con característico olor húmedo Neisseria gonorrhoeae: Colonias pequeñas grisáceas o incoloras, mucoides Neisseria meningitidis : Colonias medianas a grandes, de color azul grisáceo, mucoides. Streptococcus pneumoniae: Colonias pequeñas, planas, pueden aparecer verdes por la decoloración del medio.

MEDIO CLED El Azul de Bromotimol cambia de color por la fermentación ácida de la Lactosa. La Cistina favorece el crecimiento de las Enterobacteriáceas y el bajo contenido en electrolitos reduce la difusión de Proteus. Las peptonas, el extracto de carne y la Lactosa constituyen los elementos nutrientes del medio. E. coli en Agar CLED

AGAR MCCONKEY El Agar Mac. Conkey contiene cristal violeta y sales biliares como inhibidores de organismos Gram positivos. Las colonias aisladas de bacterias que fermentan la lactosa son rosadas y pueden estar rodeadas de una zona de precipitado de sales biliares el cual es debido a una caída en el p. H por la fermentación de la Lactosa. Las colonias que no fermentan la lactosa permanecen incoloras.

AGAR EOSINA Y AZUL DE METILENO (EMB) El uso de la eosina y del azul de metileno permite la diferenciación de las colonias fermentadoras de lactosa de las no fermentadoras. La sacarosa está incluida en el medio para detectar a los miembros del grupo coliforme que fermentan más rápidamente la sacarosa que la lactosa. Las colonias de Salmonella y Shigella son translúcidas, de color ámbar o incoloras. Los coliformes que utilizan la lactosa y/o sacarosa producen colonias de color azul a negro con centros obscuros y brillo metálico. Otros coliformes como Enterobacter presentan colonias mucosas de color rosa. Las cepas de Enterococcus faecalis son parcialmente inhibidas.

AGAR BIGGY El Extracto de Levadura, la Glicina y la Glucosa constituyen los elementos nutritivos y energéticos necesarios para el crecimiento de las variedades de Candida. El Sulfito Bismuto, que inhibe el crecimiento de la flora secundaria, es reducido a sulfuro por la acción del germen, dando lugar a colonias pardas, que en algunos casos determinan que, alrededor de la colonia, el medio también presente el mismo color.